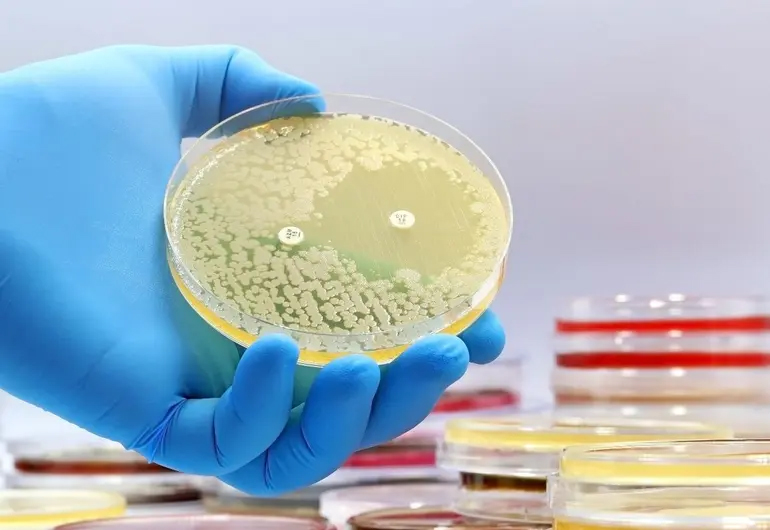

Servicios AINI
Ciudad de México, Noviembre 11.- Las superbacterias resistentes a los antibióticos se han convertido en una de las mayores amenazas para la salud pública mundial. Frente a esta crisis, los científicos exploran nuevas estrategias y recuperan compuestos naturales olvidados, como la Methylenomycin A, un antibiótico descubierto hace más de medio siglo.
¿Qué es la Methylenomycin A y por qué vuelve a estar en el foco?
Methylenomycin A es un antibiótico natural producido por la bacteria Streptomyces coelicolor, descubierto hace más de 50 años. Su ruta de biosíntesis fue documentada en las décadas anteriores, y aunque generó interés en su momento, su desarrollo clínico no llegó a avanzar de forma significativa.
Recientemente, ha reaparecido en el centro de la investigación debido a la urgencia de nuevos antibióticos frente a la resistencia antimicrobiana.
Un estudio de la University of Warwick y la Monash University identifico que en la vía biosintética de la Methylenomycin A existe un intermedio, denominado pre‑methylenomycin C lactone, que demuestra una actividad antibacteriana mucho mayor que la de la MMA original.
Este hallazgo ha vuelto a colocar al compuesto en el foco de la medicina y la investigación como posible camino para combatir bacterias resistentes.
¿Cómo actúa la Methylenomycin A frente a bacterias resistentes y qué hallazgos recientes existen?
Methylenomycin A ejerce su acción principalmente sobre bacterias Gram-positivas. No obstante, su potencia y alcance se consideran limitados frente a cepas altamente resistentes como Staphylococcus aureus resistente a meticilina (MRSA) o Enterococcus faecium resistente a vancomicina (VRE).
En el estudio, los investigadores demostraron que el intermedio pre-methylenomycin C lactone es más de 100 veces más activo contra estas bacterias que la MMA.
Además, en ensayos preliminares no se observó que las bacterias desarrollaran resistencia a dicho intermedio bajo condiciones de experimentación, lo que es especialmente relevante en el escenario de la resistencia antimicrobiana.
El mecanismo —descubrir y reutilizar intermediarios biosintéticos de antibióticos conocidos— abre una nueva vía en el desarrollo de fármacos contra “superbacterias”.
La resistencia antimicrobiana (AMR, por su sigla en inglés) es considerada por la Organización Mundial de la Salud (OMS) como una de las mayores amenazas para la salud global. Parte de la solución pasa por el descubrimiento de nuevos antibióticos o versiones mejoradas de los existentes.
El hallazgo reciente alrededor de la MMA y sus derivados pone en evidencia que muchas moléculas “olvidadas” pueden reactivarse o reutilizarse gracias a avances en biología sintética y técnicas modernas.
En este contexto, la MMA y su intermedio recalcan la importancia de examinar rutas biosintéticas previamente conocidas para extraer moléculas más potentes y con menor riesgo de evasión por parte de bacterias resistentes.
Desafíos, riesgos y requisitos para que la Methylenomycin A pase de laboratorio a medicina
Aunque los resultados preliminares son prometedores, aún hay varios obstáculos antes de que la MMA (o sus derivados) puedan usarse clínicamente:
- Seguridad y toxicidad:
Toda nueva molécula antibiótica debe demostrar que es segura para humanos, sin efectos secundarios graves. Aunque se ha visto eficacia in vitro, aún se necesita evaluar toxicidad, efectos en órganos, metabolismo y otros aspectos críticos. - Producción escalable:
Los estudios indican que el intermedio pre-methylenomycin C lactone tiene una ruta de síntesis escalable, lo cual es positivo. No obstante, llevar ese proceso a escala industrial y cumplir con estándares regulatorios es un paso mayor que requiere tiempo y recursos. - Transición de in vitro a in vivo y clínica:
La mayoría de los datos actuales corresponden a ensayos de laboratorio. Faltan estudios en animales y humanos que validen eficacia, dosis, seguridad, farmacocinética y otros parámetros regulatorios. - Incentivos económicos y modelo de desarrollo:
Como señalan algunos análisis, pocas compañías farmacéuticas invierten en antibióticos nuevos debido a que el retorno financiero es bajo comparado con otros fármacos. La OMS advierte que hay “muy pocos antibacterianos en desarrollo”.
Este contexto hace que incluso hallazgos prometedores tarden en avanzar hacia el mercado. - Resistencia futura:
Aunque no se detectó resistencia al intermedio en los ensayos iniciales, la historia de los antibióticos enseña que la resistencia puede emerger con el uso extendido. Por ello, debe implementarse una vigilancia continua, uso racional del antibiótico y estrategias de combinación.
El antibiótico natural Methylenomycin A, descubierto hace más de medio siglo, vuelve a estar en el radar científico gracias al hallazgo de un intermediario, pre-methylenomycin C lactone, que muestra una potencia significativamente mayor frente a bacterias Gram-positivas resistentes como MRSA y VRE.
Convertir este avance en un tratamiento disponible para pacientes implica superar importantes retos de seguridad, producción, desarrollo clínico e incentivos económicos.
Mientras tanto, la lucha contra la resistencia antimicrobiana exige tanto innovación como prudencia en el uso de los recursos ya existentes.